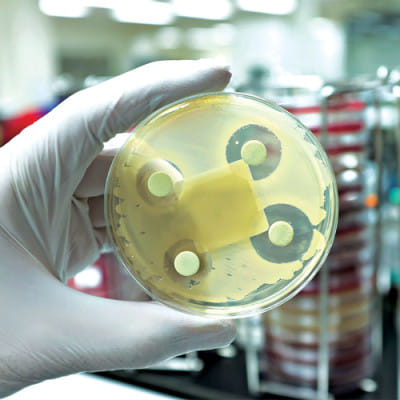

An estimated 1.2 million people died in 2019 from antibiotic-resistant bacterial infections
Antibiotic-resistant bacterial infections caused over 1.2 million lives in 2019, according to the most thorough global assessment of antimicrobial resistance (AMR).
AMR currently causes more deaths than HIV/AIDS or malaria, according to a Lancet study of 204 nations and territories, higher than HIV/AIDS or malaria. In addition, it indicates that previously treatable illnesses such as lower respiratory and bloodstream infections now cause hundreds of thousands of fatalities due to antibiotic-resistant bacteria.
The report identifies immediate policymaker steps that will assist save lives and protecting health systems. These include better monitoring and management of infections and more money for developing new antibiotics and treatments.
The new Global Research on Antimicrobial Resistance (GRAM) report estimates deaths linked to 23 pathogens and 88 pathogen-drug combinations in 204 countries and territories in 2019. In 2019, AMR was expected to be directly responsible for 1.27 million deaths and 4.95 million fatalities globally.
Also, HIV/AIDS caused 860,000 deaths, while malaria caused 640,000 in 2019. Lower respiratory infections (such as pneumonia) had the highest influence on AMR disease burden, causing over 400,000 deaths and affecting over 1.5 million.
Drug resistance in bloodstream infections caused 370,000 deaths and was linked to approximately 1.5 million deaths. Drug resistance in intra-abdominal infections (such as appendicitis) caused 210,000 fatalities directly and 800,000 indirectly. While AMR affects people of all ages, small children are particularly vulnerable, with AMR accounting for almost one in every five deaths in this age group.
Deaths caused directly by AMR were estimated to be highest in Sub-Saharan Africa and South Asia, at 24 deaths per 100,000 population and 22 deaths per 100,000 population, respectively.
AMR was associated with 99 deaths per 100,000 in Sub-Saharan Africa and 77 deaths per 100,000 in South Asia. In high-income countries, AMR led directly to 13 deaths per 100,000 and was associated with 56 deaths per 100,000.
Across all pathogens, fluoroquinolone and beta-lactam antibiotic resistance accounted for more than 70% of AMR-related mortality. S. pneumonia (16%) and K. pneumonia (20%) were the most common pathogens responsible for AMR-related mortality in Sub-Saharan Africa, while S. aureus (26%) and E. coli (50%) were responsible for AMR-related deaths in high-income nations (23%).
Because resistance varies greatly by country and location, enhancing global data collection is critical to better tracking levels of resistance and empowering clinicians and policymakers to address the most important concerns posed by antimicrobial resistance.
Source: The Lancet
Comments